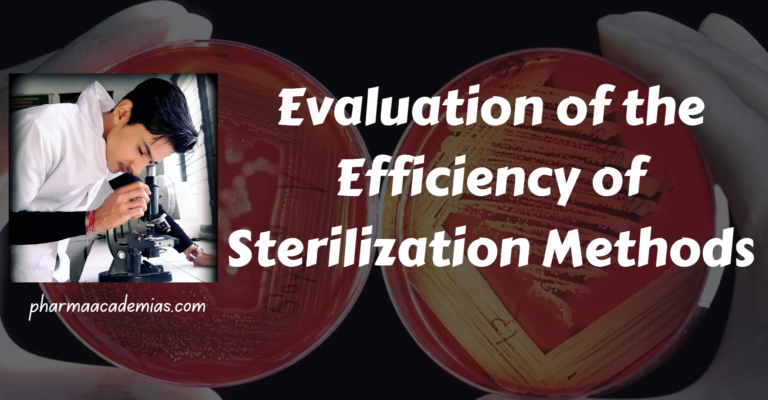
Evaluation of the Efficiency of Sterilization Methods
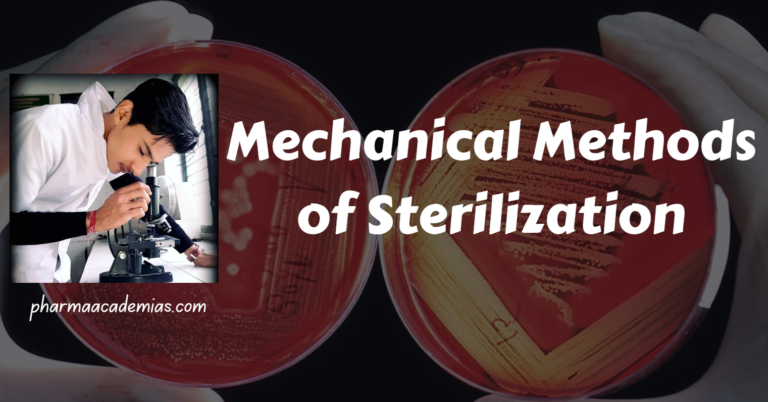
Mechanical Methods of Sterilization
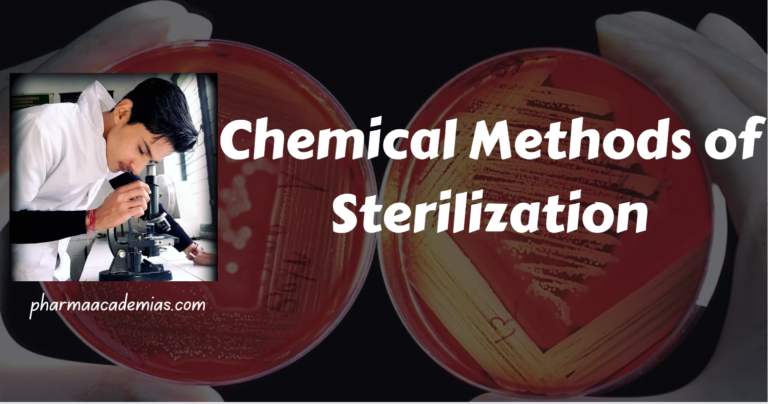
Chemical Methods of Sterilization
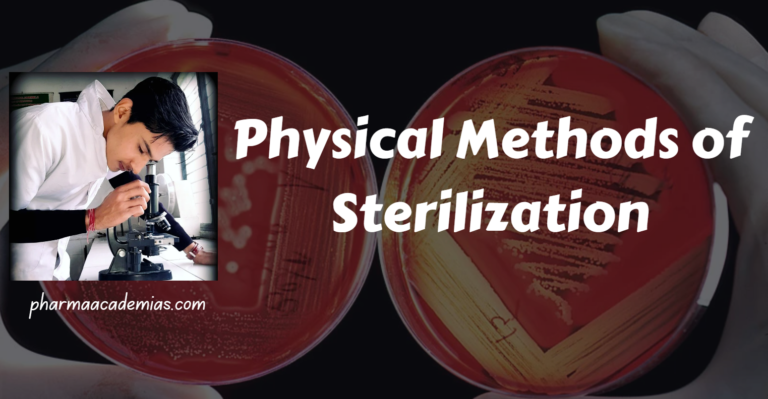
Physical Methods of Sterilization
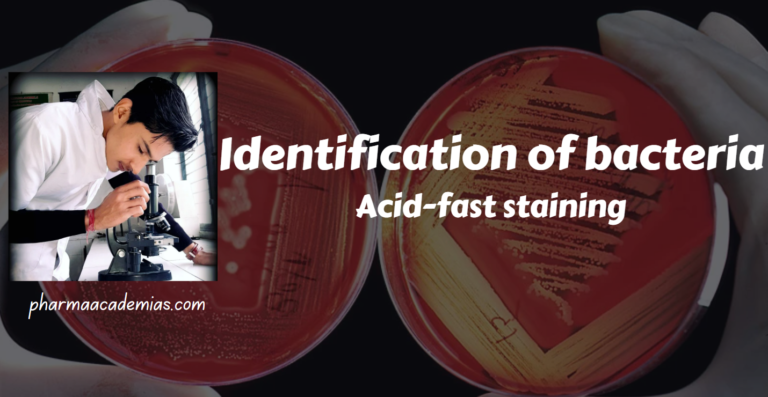
Acid-fast staining
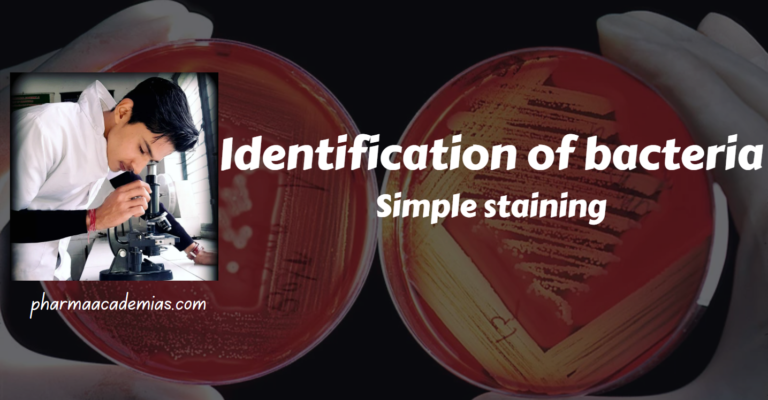
Identification of bacteria: Simple staining

Evaluation of the Efficiency of Sterilization Methods
Ensuring the effectiveness of sterilization processes is crucial in various fields, including healthcare, laboratories, and industries. The evaluation of sterilization methods involves assessing their ability to eliminate or reduce the microbial load on surfaces, instruments, or materials. Several parameters and methods are employed to determine the efficiency of sterilization. Here’s a detailed note on the…